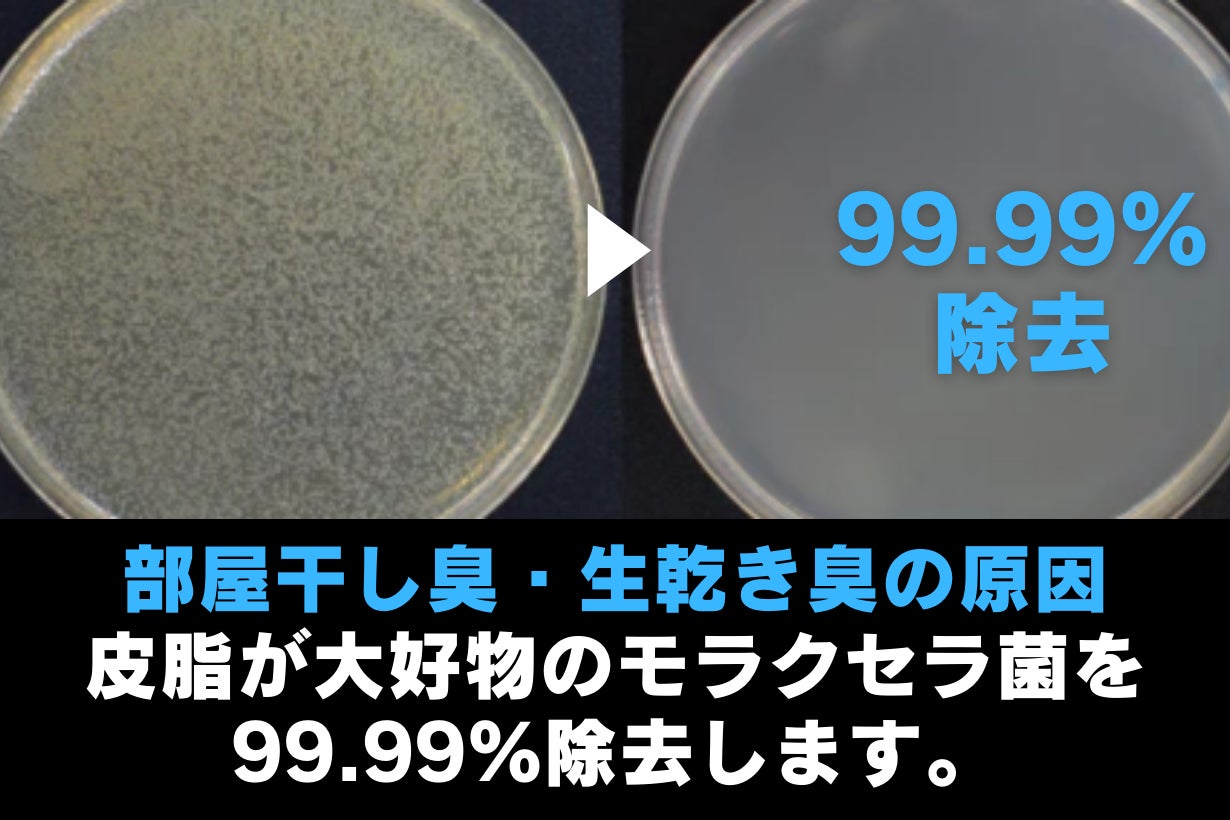

ここまでこれたのは皆様の応援ご支援のおかげです。ほんとうに有難うございました。
✅1個超早割価格:
35%OFF価格9,980円
(定価より5,380円もおトク)
✅2個セット:
53%OFF価格14,430円
(1個あたりが7,215円でさらにおトク)
✅3個セット:
55%OFF価格20,730円
(1個あたりが6,910円でますますおトク)
2つも3つも洗濯機のあるお家はそうないと思われますが、ご親族やお友達、向こう三軒両どなりとの共同購入もオススメです。
このオトクなリターンを逃さず、ご支援よろしくでござる!

忙しいズボラさんの洗濯解!
あなたの洗濯、助太刀します!

SENRENは極小気泡のマイクロバブルとナノバブルを使う二刀流。
マイクロバブルで表面の汚れに豪快にアタック!

さらに小さいナノバブルは繊細に繊維に入り込みニオイのもとを攻撃!

二刀流バブルが、イヤなものすべてを剥がし取ります!
「そんなにスゴイなら、取り付けが大変だったり、面倒なことがたくさんあるんじゃない?・・・」
それは心配ご無用です!がんばらなくても解決します!

そう!頑張るのは”忙しいズボラさんの洗濯解「SENREN」”です!

極小気泡のマイクロバブルとナノバブル。
二刀流バブルで汚れもニオイも斬ります!
このとても小さい二刀流バブルを、水1滴(1ml)に1億個発生させます。



加齢臭、ミドル脂臭、青年臭などの原因である皮脂汚れを最大91%除去します。

部屋干し臭の原因、モラクセラ菌を99.99%除去します。

洗濯物の表面と線維の中からはたらきかけて、しつこい汚れを落とします。


微細な汚れまで除去できるので、タオルなどのふんわり感がアップします。
いつもの洗剤や、セールで買った洗剤でもふわふわな肌触りが実感できます。


洗濯をしているだけで、洗濯槽がキレイになります。
忙しいズボラさんに嬉しい、二刀流バブルの副効果です。


そのために30秒だけ頑張ってください!

腐食に強くさびにくい真ちゅう製なので、一度付けてしまえば取り換える必要がありません!

(※想定された状況下でのご使用時に限ります)





▶2025年 4月 9日:プロジェクト公開
▶2025年 4月30日:プロジェクト終了
▶2025年 6月:リターン配送開始
*活動レポートにて正確な日程は報告いたします。
いつもの生活がちょっと楽しくなる製品をお届けする、INASENAグループの合同会社Ryobooです。今回の「SENREN」は、洗濯に手間も時間もかけたくないズボラさんにとってスタッフイチオシの製品です。名前は「洗練」という名詞から名付けました。「洗練」には「みがきのかかったものにすること」という意味が込められています。
INASENAグループはちょっと楽しい、ちょっと元気になる鯔背(いなせ)なプロダクトを皆様に提供したい、こだわり集団です。
私たちが自信をもってオススメする製品が、皆様にとってもお気に入りになることを励みに日々挑戦しています!
新商品情報はLINEよりご案内しておりますので是非この機会にお友達登録をお願いします!

<ご注意>※このプロジェクトで取り扱うリターン品は世界有数の水処理・浄水環境サービスプロバイダーであるBRISKSPRING社の製品15002のOEM生産です。https://www.briskspring.com/
※本プロジェクトはAll-in方式で実施します。目標金額に満たない場合も、計画を実行し、リターンをお届けします。
※本プロジェクトは4月30日(水)23:59まで行われ、2025年6月末までにお手元にお届けする予定です。
※プロジェクト終了後には迅速に配送手配を開始至します。
※ご注文状況、使用部材の供給状況、製造工程上の都合等により出荷時期が遅れる場合があります。その際は、活動レポートにてご報告させていただだきます。
※製品は中国から弊社倉庫へ輸入し、検品後、皆様へ国内配送を行います。弊社倉庫到着後は1週間程度でお届けすることを予定しています。尚、国内倉庫までは通常1週間程度で到着する予定ですが、通関手続きや疫病による物流混乱等により遅延が発生し、1ヶ月を超える場合もございます。その後、一般販売をする予定です。
※クラウドファンディングの性質上、配送遅延のおそれがございますが、原則として、ご支援のキャンセルはできません。あらかじめご理解とご了承いただいた上でご支援くださいますよう、よろしくお願い申し上げます。
———
■特定商取引法に関する記載
●販売事業者名: 合同会社Ryoboo
●業務の責任者の氏名:二瓶
●事業者の住所/所在地:〒160-0023 東京都新宿区西新宿3-3-13西新宿水間ビル6階
●事業者の連絡先:Tel: 03-6683-3137 Mail: info@ryoboo.com
———
●リターン価格:各リターン記載の通り *商品内容についてはリターン欄記載の通り※リターン価格とは別にCAMPFIREのシステム利用料として1支援毎に、支援金額1万円未満の場合は250円(税込)/ 1万円以上の場合は支援額の2.5%(税込)が支援者様の負担となります。※上記システム利用料はCAMPFIREが受け取るもので、当社が受領するものではございません。
●送料:送料込み
●対価以外に必要な費用:プロジェクトページ、リターンに記載のとおり。
●支払い方法:CAMPFIREの決済手段に準ずる (詳細はこちら)
●支払い時期:当プロジェクトは「All-in型」の為、目標達成の如何に問わず、ご契約が成立しリターンをお届けします。その為、お申込みと同時にご利用の決済方法に準じてご請求となります。
●引渡し時期: 各リターン詳細に記載の発送予定月を引き渡し時期とします。但し、開発・生産状況によって遅れが生じる場合がありますのでその際は当プロジェクトページ内の「活動報告」または購入者へのメール等で連絡します。
●キャンセル・返品: 当プロジェクトは「All-in型」の為、お申込み完了をもって契約が成立いたします。その為、お客様都合による返品・キャンセルはできませんのでご注意ください。尚、製品到着後に破損や初期不良がある場合には交換させていただきますので「メッセージで意見や問い合わせを送る」から、または納品書記載の連絡先までお問い合わせください。●ソフトウェアに係る取引である場合のソフトウェアの動作環境:該当なし
●その他記載事項:プロジェクトページ、リターン記載欄、共通記載欄をご確認ください。
●並行並行輸入品が発生する可能性があります。正規以外での個人輸入等は、完全に防ぐことができない場合がございます旨、予めご了承のほどお願いいたします。 並行輸入品は正規代理店による製品保証を受けることができません。 また、正規代理店を通じて購入することで、日本国内での流通に必要な各種認証の取得や、関税の適切な処理が担保されます。
最新の活動報告
もっと見る
【御礼】直冷えマット1,870万円突破!そして新たな挑戦へ
2026/06/18 19:00過去・現在を通じて、私たち INASENA Gr. のプロジェクトにお気に入り登録してくださっている皆さまへの配信です。重複して配信されている場合もあるかもしれませんが、ご容赦いただけますと幸いです。現在公開中のプロジェクト「電気代はエアコンの1/80(1日1.5円)|水循環システム搭載の直冷えマット」多くの皆さまからのご支援のおかげで、まもなく支援額1,870万円を突破しました(本日17:00現在)本当にありがとうございます。また、お気に入り登録も1,600件を超え、多くの方に関心をお寄せいただいていることを大変嬉しく感じています。暑さ対策という身近なテーマだからこそ、「寝苦しい夜を少しでも快適にしたい」そんな皆さまのお声や応援メッセージに支えられながら、日々プロジェクトを運営しています。改めて、心より御礼申し上げます。そして本日は、もうひとつご報告があります。実は、新しいプロジェクトを公開しました。その名も【芳醇 HOJUN】です。「待たずに、芳醇。」超音波熟成器 HOJUN | いつものお酒を、もっと美味しく。今回は、直冷えマットとはまったく異なるジャンルへの挑戦です。超音波の力を利用して、・ワイン・日本酒・ウイスキー・カレー・お醤油・コーヒーなどの風味変化を楽しむための製品です。正直なところ、「本当に変わるの?」と思われる方も多いと思います。私自身も最初は半信半疑でした。ですが実際に試してみると、お酒だけでなく、カレーやお醤油などでも予想以上に面白い変化を感じることができました。もちろん、すべての方に必要な商品ではありません。ただ、・お酒が好きな方・料理が好きな方・コーヒーが好きな方には、きっと興味を持っていただける内容だと思っています。もしご興味がありましたら、ぜひ一度プロジェクトページを覗いてみてください。今後も皆さまに面白い商品や新しい体験をお届けできるよう、挑戦を続けてまいります。引き続きどうぞよろしくお願いいたします。 もっと見る熱帯夜 となりスヤスヤ オレ汗だく
2026/05/02 12:00こんにちは。ただいまわたしたちが公開しているふたつのプロジェクトを紹介させてください。どちらも、これからの夏本番に備える対策グッズです。①波長光×超音波, カラビナ×リストバンドW二刀流虫よけアイテム②電気代エアコンの1/20水循環冷却ギア直冷えマットもしご興味ご関心がございましたら、クリックしてのぞいてくれると嬉しく思います。(余談)熱帯夜となりスヤスヤおれ汗だく主導権むかしテレビでいまクーラー②の公開にあたり、わたしたち素人スタッフが詠んだ川柳を、公開ページにちらっと載せてます。皆様の連休中の骨休めに、もし、ひらめいた詩歌がありましたらご一報くださると嬉しいです。公開ページや活動報告で紹介させていただきます。*過去に、わたしたちのプロジェクトにご支援、関心を寄せてくださった皆様に配信しております。重複して配信されている場合はご容赦くださいませ。 もっと見る
新しい虫よけグッズのご紹介
2026/04/20 12:0012:00より公開となりました!お散歩にジョギング、ガーデニングやキャンプ。アウトドアシーズンに向けての虫よけ対策グッズです。赤ちゃんやペットにも安心して使えます。スタッフ全員が気に入ったアイテムをご覧いただけると嬉しいです。https://camp-fire.jp/projects/941624**過去にわたしたちのプロジェクトにご支援くださいました皆様、お気に入り登録してくれた皆様に配信されています。 もっと見る









コメント
もっと見る